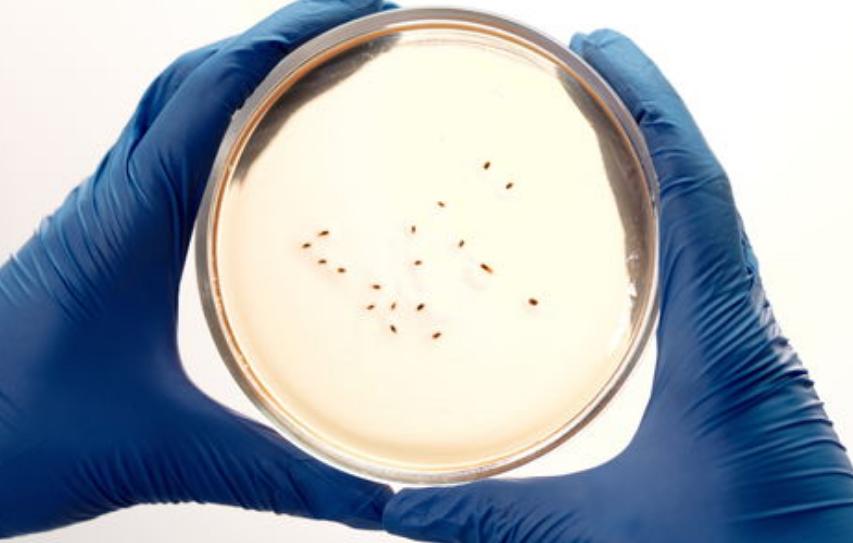
*013院医**教授：少吃点肉吧！太多人因它而受罪，是时候醒悟了

要想保持健康的身体,以及均衡的膳食结构,中老年人每日所需摄入的肉类究竟有多少? 北京第*013院医**赵霖教授有一段生动的话,他说: 考古学家从恐龙的牙齿辨别其是草食还是肉食类动物。 这一道理同样可以用在人身上。
正常人有32颗牙齿,前面8颗是用来切割蔬菜、瓜果的,后面20颗是用来研磨粮食、豆子的,只 有4颗*牙虎**是用来吃肉的! 因此,中老年人应该少吃肉。
这个观点正确吗?到底应该如何健康食用肉类?有哪些需要考虑的事项?今日,我们将通过资料分析,来回答上述问题!

一、中老年人应该少吃点肉吗?为何?告诉你答案
中老年是身体患病的高发期,不少人会减少肉类的摄入,害怕一不小心肉吃得太多,会提高患病的风险。这种想法有没有科学根据呢? 有调查显示,少吃肉的确可以减少患上癌症的概率。
1.新研究:少吃肉或可减少癌症的发生
牛津的科研小组最近在专门的医学杂志《BMC Medicine》上刊登了一份关于健康的研究报告, 有调查显示,只吃鱼和蔬菜 , 相比较只吃肉的人,得癌的概率较低。
那这个问卷是如何得到的?
研究人员对472,777位英国生物银行的志愿者开展调查,将被测试人员分成4个小组:

A组:普通肉食者:每周吃红肉、禽肉及加工肉制品超过5次,共有247571人。
B组:以少肉类为主,人数为205385名,一周食用肉类5次以内。
C组:以鱼类为主,人数为10696名。
D组:素食者,不吃肉的人数为8685人。
这项调查追踪了受试者11.4年, 结果显示,共有54961名新发癌症患者,在进行了分析之后发现, 相对于普通的肉食主义者,吃鱼类吃和素食者的患癌风险,分别下降了10%和14%。

从上述研究成果中,我们可以得出一个结论,那就是天天食用肉类的人得癌的概率较高,而那些不多食肉类,多食鱼类,以及素食主义者,得癌的可能性就会低很多。 这意味着,减少肉类摄入确实能减少罹患癌症的可能 。
那么,到底是什么原因造成红肉食用过量而导致癌症呢? 中老年人应该怎么选择吃什么肉更由于健康?
2.多吃红肉和加工肉有哪些致病因素?
2015年,WHO(世界卫生组织)提出的关于红肉及加工肉的研究结果显示, 红肉是2*级A**,具有可能的致癌风险,而加工肉类是1A,具有很强的致癌性。

具体来说,红肉是指像羊肉、牛肉、猪肉、马肉等各种哺乳类的肉; 加工肉类指的是经过腌制、固化、发酵、熏制、增加香味或进行其他改良后的肉类 ,例如热狗、肉类罐头、肉类配料等。
(1)红肉和加工肉吃多了易引发直肠癌
有资料显示,每天食用超过50g的红肉或加工肉,患上大肠癌的风险就会提高18%。
对于红肉以及经过处理的肉制品,有些专家对其致癌机理进行了研究。在实验中,研究者观察到:红色肉类中含有的 血红素铁会导致结肠上皮细胞发生不正常的增殖,使得结直肠癌的发病风险随之增加;
在对肉进行加工时,为了延长肉的保鲜时间,通常要加入亚硝酸盐,容易导致人体产生致癌物质亚硝胺; 另外,肉类在加热后会产生致癌物质如多环芳烃。 因此,食用红肉及加工肉制品,容易引发大肠癌。

(2)红肉和加工肉容易引发25种疾病
2021年,据英国牛津大学开展的一项针对5万人的研究表明, 吃大量牛羊肉或加工肉后会引起25种疾病,包括心脏病、糖尿病、出血性中风等 。
研究者发出警告:每日吃85克的牛肉和羊肉,其患心脏病的风险提高了15%。
本课题以美国医疗机构(NIH)多年来对中国人群进行的心脏健康状况调研为基础,对3931名非冠状动脉疾病病人的血样进行了采集和分析。

项目的负责人说, 我们日常所吃的肉制品中含有膳食肉碱,经过肠内微生物的作用, 会被肠道菌群分解,产生一种叫做γ-丁基甜菜碱的物质,然后快速转变三甲胺氧化物,这种代谢物是引起心血管疾病的“罪魁祸首”。
经过12.5年的跟踪调查,研究者们发现,在大多数病例中, 氧化 三 甲胺的含量与死亡率的增加有很强的正比关系, 氧化三甲胺的比例越高, 血管壁的厚度和硬化程度就会越高。
用直观的数字表示 : 每多食用85克红肉或加工肉,这将使动脉粥样硬化症和心脑血管疾病的发病风险分别增加11%和15%。
所以,营养师们提醒, 在日常生活中,老人应该多吃蔬菜禽肉和鱼类,尽量少吃红肉和加工肉。

二、少吃肉不等于不吃肉!长期不吃肉危害有多大?
医生提醒要尽量减少肉类的摄入量,所以很多人都会错误地认为, 对于中老年人来说,最好是不吃肉类,多吃蔬菜、水果就行了。其实,这样的想法是不对的。
由于肉是人类必不可少的食物, 它包含了很多植物蛋白质所不含的氨基酸,不吃肉将给人带来很大的危害。
1.英国研究者:肉吃得越少,骨折的风险越大
一份由英国牛津大学发表在《BMC Medicine》的调查报告, 在经过经过17年的追踪后 ,研究人员得出统计数据,在超过50万名患者中,总共有3941名患者患有严重的骨折。

与肉食主义者比较,素食者的钙质和蛋白质摄取量更低, 具有 更低的体重指数和更少的身体脂肪, 因此当他们摔倒的时候,很有可能会因为没有缓冲的力量而摔断骨头。
素食者 总体骨折发生率较高,比吃肉的人高出43%,大腿及其他重要区域局部骨折发生率更高。 因此,我们要保证充足的钙质和蛋白的摄入,同时保持身体正常的体重指数,防止骨折。

对于中老年人来说,不仅要保持骨骼的健康,更要重视大脑的健康,根据另一项研究显示,不食肉类,还会增加中老年人失智和患上中风的概率。
2.法国一项新的调查:不食肉会使人失智的概率增加67%
法国国家健康机构,在2019年出版的一本关于阿兹海默症的杂志上刊登了一篇文章: 少量吃肉会提高患痴呆的风险!

本研究共收集了3个区域的5934名年龄超过65岁研究对象的数据,经过9.8年的研究,共收集到662名老年失智症病人,包括466名老年阿兹海默症病人饮食习惯参数。
他们发现,每周食用4次以上肉类的人群,与那些一星期食用一次肉类的人相比, 前者 出现失智症的概率要高58%,出现阿兹海默症的概率要高67%。
这到底是为什么呢?
很多研究表明, 阿兹海默病人其脑内的乙胆碱含量明显低于正常人群。乙胆碱是一种具有神经传导作用的物质,参与大脑中的神经元传递,乙胆碱主要靠胆碱产生,而胆碱主要来自牛奶、鸡蛋和肉类。

缺少乙胆碱就会导致很多器官出现问题, 例如大脑的认知功能、神经系统的功能、肝脏的功能等。与此同时,有关的研究也证实,不吃肉不但会导致阿尔兹海默病,而且还会增加卒中的危险。
3、素食者中风的可能性比肉食者高20%?
牛津大学的一份调查显示,与肉食主义者相比,长期素食主义者患上中风的风险要高出20%。
该调查持续了18年,其中有50,000名成年人参与。 调查显示,素食主义者体内胆固醇含量较低, 并且 缺乏维他命B12、维生素D、氨基酸、不饱和脂肪酸等物质, 因此会增加中风危险。

以缺乏维生素B12为例,这一营养物质仅在动物性食品中才有,缺乏维生素B12,容易 导致血液中的半胱胺酸蓄积, 造成动脉硬化,使血管变得更细,或是使病变的组织发生破裂,从而产生血栓, 导致中风的 发生。
而我们要知道,富含维生素B12的食物主要集中在贝类、牛肝、鸡蛋、鱼类、肉类、牛奶等食物中。 所以,在饮食方面,对于老人来说,千万不要过分限制肉类的摄入,一定要保证营养的均衡。
三、中老年人应该吃什么肉?如何科学吃肉?
中老年人不能不吃肉,那么应该吃什么肉,怎么吃肉更有利于健康呢?在肉的种类和烹饪方法上应该注意些什么呢?有数据显示,科学吃肉对身体益处多多。

1.老人应该多吃白肉
白肉主要是指鱼类、虾类、贝、鸡鸭类等肉类,白肉具有较高不饱和脂肪酸,且含有较少脂肪!
以长寿著称的日本人,最喜欢的食物就是鱼肉。日本一项研究发现, 海产的鱼肉富含Omega-3脂肪酸,这种物质属于多元不饱和脂肪酸,是一种对大脑发育、血管弹性、身体免疫力等有益的物质, 但这种物质身体自身是不能合成的,只能从深海鱼类中获取。
老年人随著年纪的增长,患上心脑血管疾病的机率也会随之上升。鱼中大量的Omega-3脂肪酸, 能够降低人体中的胆固醇 ,同时 还能改善高血脂、血管堵塞等症状 ,降低心脑血管的负担, 舒缓忧伤、抑郁等消极情绪 ,对维持中老年人生理和心理的健康大有裨益。

2.摄入多种蛋白,反而能降低血压
近期,一份针对中国人的调查报告,刊登在《Hypertension》杂志上, 向我们展示了 摄入多种蛋白(即以蛋白为主的肉类)与高血压之间的关系,为科学食用肉类提供了指导。
调查针对12,177位中国人的饮食进行了六年的跟踪调查,其中35%以上的人在接受调查时患有高血压。
通过比较有高血压的人群和正常人群的饮食,研究发现,蛋白质来源的多样性与高血压发病风险呈负相关, 也就是说吃的 蛋白种类越多,患上高血压的风险将越低,每多吃一种蛋白,高血压风险会下降26%。

那为何食用更多的蛋白质可以帮助减少血压呢?
该报告的结论是: 通过多吃鱼肉、豆类和蛋类,摄入多种类的蛋白质, 可以保证摄入不同的必需氨基酸,确保微生物群的丰富性和多样性,能够防治脂代谢紊乱、心血管病等 。 因此中老年人要科学地吃肉,同时还要注重合理的肉食搭配。
除此之外,还有一项研究表明,烹调技巧对身体健康也很重要。
3.肉类的烹调方式不对,会增加Ⅱ型糖尿病的风险
美国2018年曾在国际知名的糖尿病杂志上进行过一项调查,这项调查统计了50,000多位妇女,每月吃煎炸和烧烤肉的频率。
研究表明: 每月食用15次以上的油炸烧烤肉类的人群,要比每月食用4次以上的油炸烧烤肉类的人群,患 Ⅱ型糖尿病的概率要高28%。
对于其中原因,研究者们认为这是由于在较高温度下烹饪食品, 容易产生过量的致癌物质杂环芳基胺,该物质可以通过诱发炎症和与糖尿病有关的信号途径,导致糖尿病的发生,促成Ⅱ型糖尿病的形成。
因此,在烹饪肉类食品的时候,要尽可能避免使用温度较高的烹饪方法,也要避免使用油炸、烤等不卫生的食用方法,可以多用炖、煮、汆等方法食用,这样有利于预防慢性病。
通过以上研究报告分析,我们可以了解到: 中老年人要少吃肉,但不能不吃肉,吃肉时要注意科学搭配,采用合适的烹饪方式,如此才能保持健康良好的体质。
参考文献:
[1] 吃饭听听*013院医**这位军医的话!你就长了4颗*牙虎**是吃肉用的,吃那么多肉干什么啊!健康时报.2019-02-28
[2]《BMJ》子刊:素食主义者注意!长期吃素或不利大脑健康.国际科学.2019-09-02
[3]放肆吃肉的代价:近50万人研究发现,常吃肉与25种疾病相关.生命时报.2021-03-23